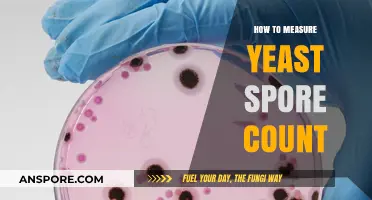
Mastering Yeast Spore Counting: Accurate Techniques for Optimal Results

Mo spore, short for Mycelium Running: How to Grow Your Own Mycorrhizal Fungi, refers to the process of cultivating beneficial fungal spores, particularly mycorrhizal fungi, to enhance soil health, plant growth, and ecosystem resilience. These fungi form symbiotic relationships with plant roots, improving nutrient uptake, water absorption, and disease resistance. To mo spore, one typically collects spores from healthy fungi, prepares a suitable substrate like wood chips or soil, and inoculates it with the spores under controlled conditions. This practice is gaining popularity in permaculture, gardening, and ecological restoration as a sustainable way to boost plant vitality and restore degraded landscapes. Whether for personal gardening or large-scale land rehabilitation, mastering the art of mo spore can transform how we nurture and interact with the natural world.
| Characteristics | Values |
|---|---|
| Spore Type | Mo (Morchella) Spores |
| Optimal Temperature for Growth | 15-25°C (59-77°F) |
| Substrate | Wood chips, straw, compost, or soil rich in organic matter |
| pH Range | 6.0-8.0 (slightly acidic to neutral) |
| Humidity Requirement | 80-90% relative humidity |
| Light Requirement | Indirect or low light (not direct sunlight) |
| Spawn Run Time | 4-6 weeks (time for mycelium to colonize substrate) |
| Fruiting Conditions | Cooler temperatures (10-18°C or 50-64°F), increased fresh air exchange, and light watering |
| Fruiting Time | 1-3 weeks after inducing fruiting conditions |
| Harvest Time | When caps are fully developed but before spores drop |
| Storage of Spores | Refrigerate at 2-4°C (36-39°F) in a sterile, airtight container |
| Shelf Life of Spores | Up to 2 years when stored properly |
| Common Challenges | Contamination, improper humidity, and temperature fluctuations |
| Uses | Culinary (edible morel mushrooms), ecological restoration, and mycoremediation |
| Safety Precautions | Sterilize equipment, work in a clean environment, and avoid consuming raw or undercooked morels |
What You'll Learn
- Preparation: Sterilize equipment, gather materials, ensure clean workspace for safe and effective mushroom spore collection
- Substrate Choice: Select nutrient-rich substrate like agar or grain for optimal spore germination
- Sterilization: Autoclave substrates and tools to eliminate contaminants, ensuring successful spore growth
- Inoculation: Introduce spores using sterile techniques to prevent contamination during the process
- Incubation: Maintain proper temperature, humidity, and light conditions for spore development and colonization

Preparation: Sterilize equipment, gather materials, ensure clean workspace for safe and effective mushroom spore collection
Successful mushroom spore collection hinges on a sterile environment. Even a single contaminant can derail your efforts, leading to mold or bacteria overtaking your precious spores. Think of it as a surgical procedure: you wouldn't want dust particles interfering with a delicate operation, would you? This is why sterilization is your first line of defense. Autoclaving, a process using high-pressure steam, is the gold standard for sterilizing equipment like petri dishes, scalpels, and inoculation loops. For smaller items, a 10-minute soak in a 10% bleach solution followed by thorough rinsing with sterile water can suffice. Remember, heat-sensitive materials may require alternative methods like chemical sterilization with ethanol.
Every spore collector needs a toolkit. Beyond sterilization equipment, gather your spore print (the source of your spores), a sterile scalpel or needle, a clean glass slide, and a petri dish containing nutrient-rich agar. Consider investing in a laminar flow hood, a specialized cabinet that creates a sterile airflow, minimizing airborne contamination. While not essential for beginners, it significantly increases success rates. Don't forget personal protective equipment: gloves, a lab coat, and a face mask are crucial to prevent introducing contaminants from your skin, hair, or breath.
Imagine your workspace as a cleanroom. Every surface must be spotless. Wipe down all surfaces with a 10% bleach solution, followed by a thorough rinse with sterile water. Cover your work area with a disposable, sterile drape. Minimize foot traffic and keep windows closed to reduce dust and airborne particles. If possible, choose a room with good ventilation but low traffic. Remember, even a single sneeze can introduce contaminants, so be mindful of your own hygiene during the process.
A well-prepared workspace is the foundation for successful spore collection. By meticulously sterilizing equipment, gathering the necessary materials, and creating a clean environment, you're setting yourself up for a rewarding and contaminant-free experience. Think of it as laying the groundwork for a thriving mushroom colony – the care you put into preparation directly translates to the quality of your results.
Spore's Complexity: Evidence of Intelligent Design in Nature's Blueprint
You may want to see also

Substrate Choice: Select nutrient-rich substrate like agar or grain for optimal spore germination
The substrate you choose is the foundation of your spore germination success. Think of it as the fertile soil for your microscopic seeds. Nutrient-rich options like agar and grain provide the essential building blocks spores need to awaken from dormancy and thrive.
Agar, a gelatinous substance derived from seaweed, is a laboratory favorite for its clarity and consistency. Its sterile nature prevents contamination, allowing you to observe the germination process with precision. Grain, on the other hand, offers a more naturalistic approach. Rye berries, for instance, are a popular choice due to their high starch content, which fuels spore growth.
Selecting the right substrate depends on your goals. For scientific observation and controlled experiments, agar's sterility and transparency are ideal. If you're aiming for a more natural, large-scale cultivation, grain substrates provide a cost-effective and nutrient-dense environment.
Remember, the substrate is more than just a surface; it's the lifeblood of your spore germination endeavor. Choose wisely, and your spores will thank you with vibrant growth.
Let's delve into the practicalities. For agar plates, a common recipe involves dissolving 20 grams of agar powder in 1 liter of distilled water, then adding a nutrient source like malt extract or potato dextrose. Autoclave the mixture to sterilize it before pouring it into Petri dishes. For grain substrates, soak your chosen grain (rye berries, wheat berries, etc.) overnight, then boil until slightly softened. Drain, cool, and sterilize before inoculating with your spore solution.
Do Ferns Have Spores? Unveiling Their Unique Reproduction Process
You may want to see also

Sterilization: Autoclave substrates and tools to eliminate contaminants, ensuring successful spore growth
Contaminants are the silent saboteurs of spore cultivation, lurking in substrates and tools to derail even the most meticulously planned projects. Autoclaving, a process that harnesses the power of steam under pressure, is the gold standard for sterilization in this context. By subjecting materials to temperatures of 121°C (250°F) and 15 psi for 15-30 minutes, autoclaves obliterate bacteria, fungi, and spores, ensuring a pristine environment for your desired spores to thrive. This method is particularly crucial when working with organic substrates like grain or manure, which naturally harbor microorganisms that compete with or prey on your target species.
The autoclaving process begins with proper preparation. Substrates should be moistened to a field capacity of 60-70% to facilitate steam penetration and prevent scorching. Tools, such as scalpel blades, inoculation loops, and jars, must be cleaned and placed in heat-resistant containers or wrapped in autoclave-safe paper. Overloading the autoclave should be avoided, as it can lead to uneven sterilization. Once the cycle is complete, allow the materials to cool naturally; opening the autoclave prematurely can cause dangerous steam burns and compromise sterility.
While autoclaving is highly effective, it’s not without its nuances. For instance, certain substrates, like sawdust or straw, may require longer sterilization times due to their bulk density. Additionally, over-saturating substrates with water can lead to anaerobic conditions, which may not be suitable for all spore species. A practical tip is to use a pressure cooker as a makeshift autoclave for small-scale operations, though it lacks the precision and consistency of a dedicated autoclave. Always verify sterilization success by incubating a control sample; if contaminants appear, re-evaluate your technique or equipment.
The persuasive case for autoclaving lies in its reliability and reproducibility. Unlike chemical sterilization methods, which may leave residues or fail to penetrate deeply, autoclaving provides a thorough, residue-free solution. This is especially critical in spore cultivation, where even a single contaminant can outcompete your desired species, wasting time and resources. Investing in proper sterilization techniques not only safeguards your experiments but also elevates the quality and consistency of your results, making autoclaving an indispensable tool in the spore cultivator’s arsenal.
Understanding Mold Spores: Causes, Health Risks, and Prevention Tips
You may want to see also

Inoculation: Introduce spores using sterile techniques to prevent contamination during the process
Spores are resilient, but the inoculation process is delicate. A single contaminant can derail your entire cultivation effort. Sterile technique is your shield against unwanted bacteria, fungi, and other microorganisms that thrive in the same conditions as your desired species. Think of it as creating a microscopic safe haven for your spores to germinate and flourish.
Every step, from preparing your substrate to sealing your container, requires meticulous attention to cleanliness.
The Sterile Arsenal: Your tools are your first line of defense. Autoclaving, a process using steam under pressure, is the gold standard for sterilizing equipment like needles, scalpels, and containers. For smaller items, flaming with a Bunsen burner or alcohol lamp can be effective, but exercise extreme caution to avoid accidents. Work in a clean, clutter-free environment, ideally with a laminar flow hood to create a sterile air current. Even your hands become potential contaminants – use sterile gloves and disinfect work surfaces with 70% isopropyl alcohol.
The Inoculation Dance: Imagine a surgeon's precision. With your sterile needle, carefully withdraw a small amount of spore solution from your syringe. Gently insert the needle into your sterilized substrate, making a shallow incision. Slowly deposit a droplet of spore solution, ensuring it's fully absorbed. Repeat this process at several points, spacing them evenly to encourage even colonization.
Dosage and Dilution: Less is often more. A single droplet of spore solution, roughly 0.1-0.2 ml, is typically sufficient for inoculating a small jar or bag of substrate. Over-inoculation can lead to competition and stunted growth. If your spore solution is highly concentrated, consider diluting it with sterile distilled water to achieve the desired dosage.
Patience is a Virtue: After inoculation, resist the urge to constantly check on your spores. Seal your container and provide optimal conditions for growth – darkness, warmth, and humidity. Germination can take days or even weeks, depending on the species. Trust the process, maintain sterility, and soon you'll witness the magical transformation from dormant spore to thriving mycelium.
Ants, Orchids, and Spores: Unraveling Nature's Intricate Spiking Secrets
You may want to see also

Incubation: Maintain proper temperature, humidity, and light conditions for spore development and colonization
Spores are remarkably resilient, but their transformation into thriving mycelium networks hinges on precise environmental control during incubation. Temperature acts as the primary catalyst, with most mushroom species favoring a range between 70-75°F (21-24°C) for optimal colonization. Deviations of more than 5°F can significantly slow growth or even halt it entirely, making a reliable thermostat or temperature-controlled environment essential. For tropical species like *Pleurotus ostreatus* (oyster mushrooms), slightly higher temperatures around 75-80°F (24-27°C) may be beneficial, while cooler-climate varieties like *Agaricus bisporus* (button mushrooms) thrive at the lower end of the spectrum.
Humidity, often overlooked, is equally critical. Spores require moisture to germinate and for mycelium to spread, but excessive dampness invites contamination. Aim for a relative humidity of 60-70% during incubation, achievable with a humidifier or by misting the substrate lightly. However, avoid direct water contact with the spores, as this can drown them or create pockets of anaerobic conditions. A simple yet effective method is to place a tray of water near the incubation chamber, allowing evaporation to maintain consistent moisture levels without saturating the environment.
Light, though not a primary driver of spore development, plays a subtle yet important role. While spores themselves do not require light to germinate, mycelium often benefits from indirect, low-intensity illumination once colonization begins. This mimics the natural conditions of forest floors, where mushrooms grow in dappled light. Avoid direct sunlight, which can overheat the substrate and dry it out, but do not incubate in complete darkness, as this can lead to abnormal growth patterns. A 12-hour photoperiod with soft, artificial light is ideal for most species.
Maintaining these conditions requires vigilance and adaptability. Fluctuations in temperature or humidity can stall growth or introduce contaminants, so regular monitoring is crucial. Use digital hygrometers and thermometers for accuracy, and consider investing in a small incubator or environmental chamber for consistent results. For hobbyists, a repurposed storage container lined with aluminum foil and equipped with a heating pad and humidifier can suffice, provided the setup is monitored closely. Remember, incubation is a delicate balance—too much control can be as detrimental as too little, so observe your setup daily and adjust as needed.
Finally, patience is paramount. Colonization can take anywhere from 7 to 21 days, depending on the species and conditions. Resist the urge to disturb the substrate during this period, as even minor disruptions can set back growth. Signs of successful incubation include uniform white mycelium spreading across the substrate, indicating that the spores have germinated and are establishing a healthy network. Once colonization is complete, the substrate is ready for the next stage of fruiting, where mushrooms will begin to form under adjusted environmental conditions.
Bypassing Firewall Restrictions: A Guide to Accessing Spore Smoothly
You may want to see also
Frequently asked questions
Mo spore refers to the process of cultivating mycelium-based materials, often used in sustainable products like packaging, leather alternatives, and textiles. It’s important because it offers an eco-friendly alternative to traditional materials, reducing reliance on plastics and animal products.
You’ll need a substrate (e.g., sawdust, straw, or agricultural waste), mycelium spores or starter culture, a sterile container, and tools for mixing and maintaining humidity, such as a spray bottle and plastic wrap.
The growth time varies depending on the substrate and conditions, but it typically takes 1-3 weeks for mycelium to fully colonize the material. Factors like temperature, humidity, and ventilation can influence the timeline.
Yes, certain types of mycelium can be used to create edible products like mushroom-based meats or fermented foods. However, ensure the species is safe for consumption and follow proper hygiene practices.
Common mistakes include using contaminated materials, not maintaining proper humidity, and exposing the mycelium to direct sunlight. Sterilization and consistent environmental conditions are key to success.